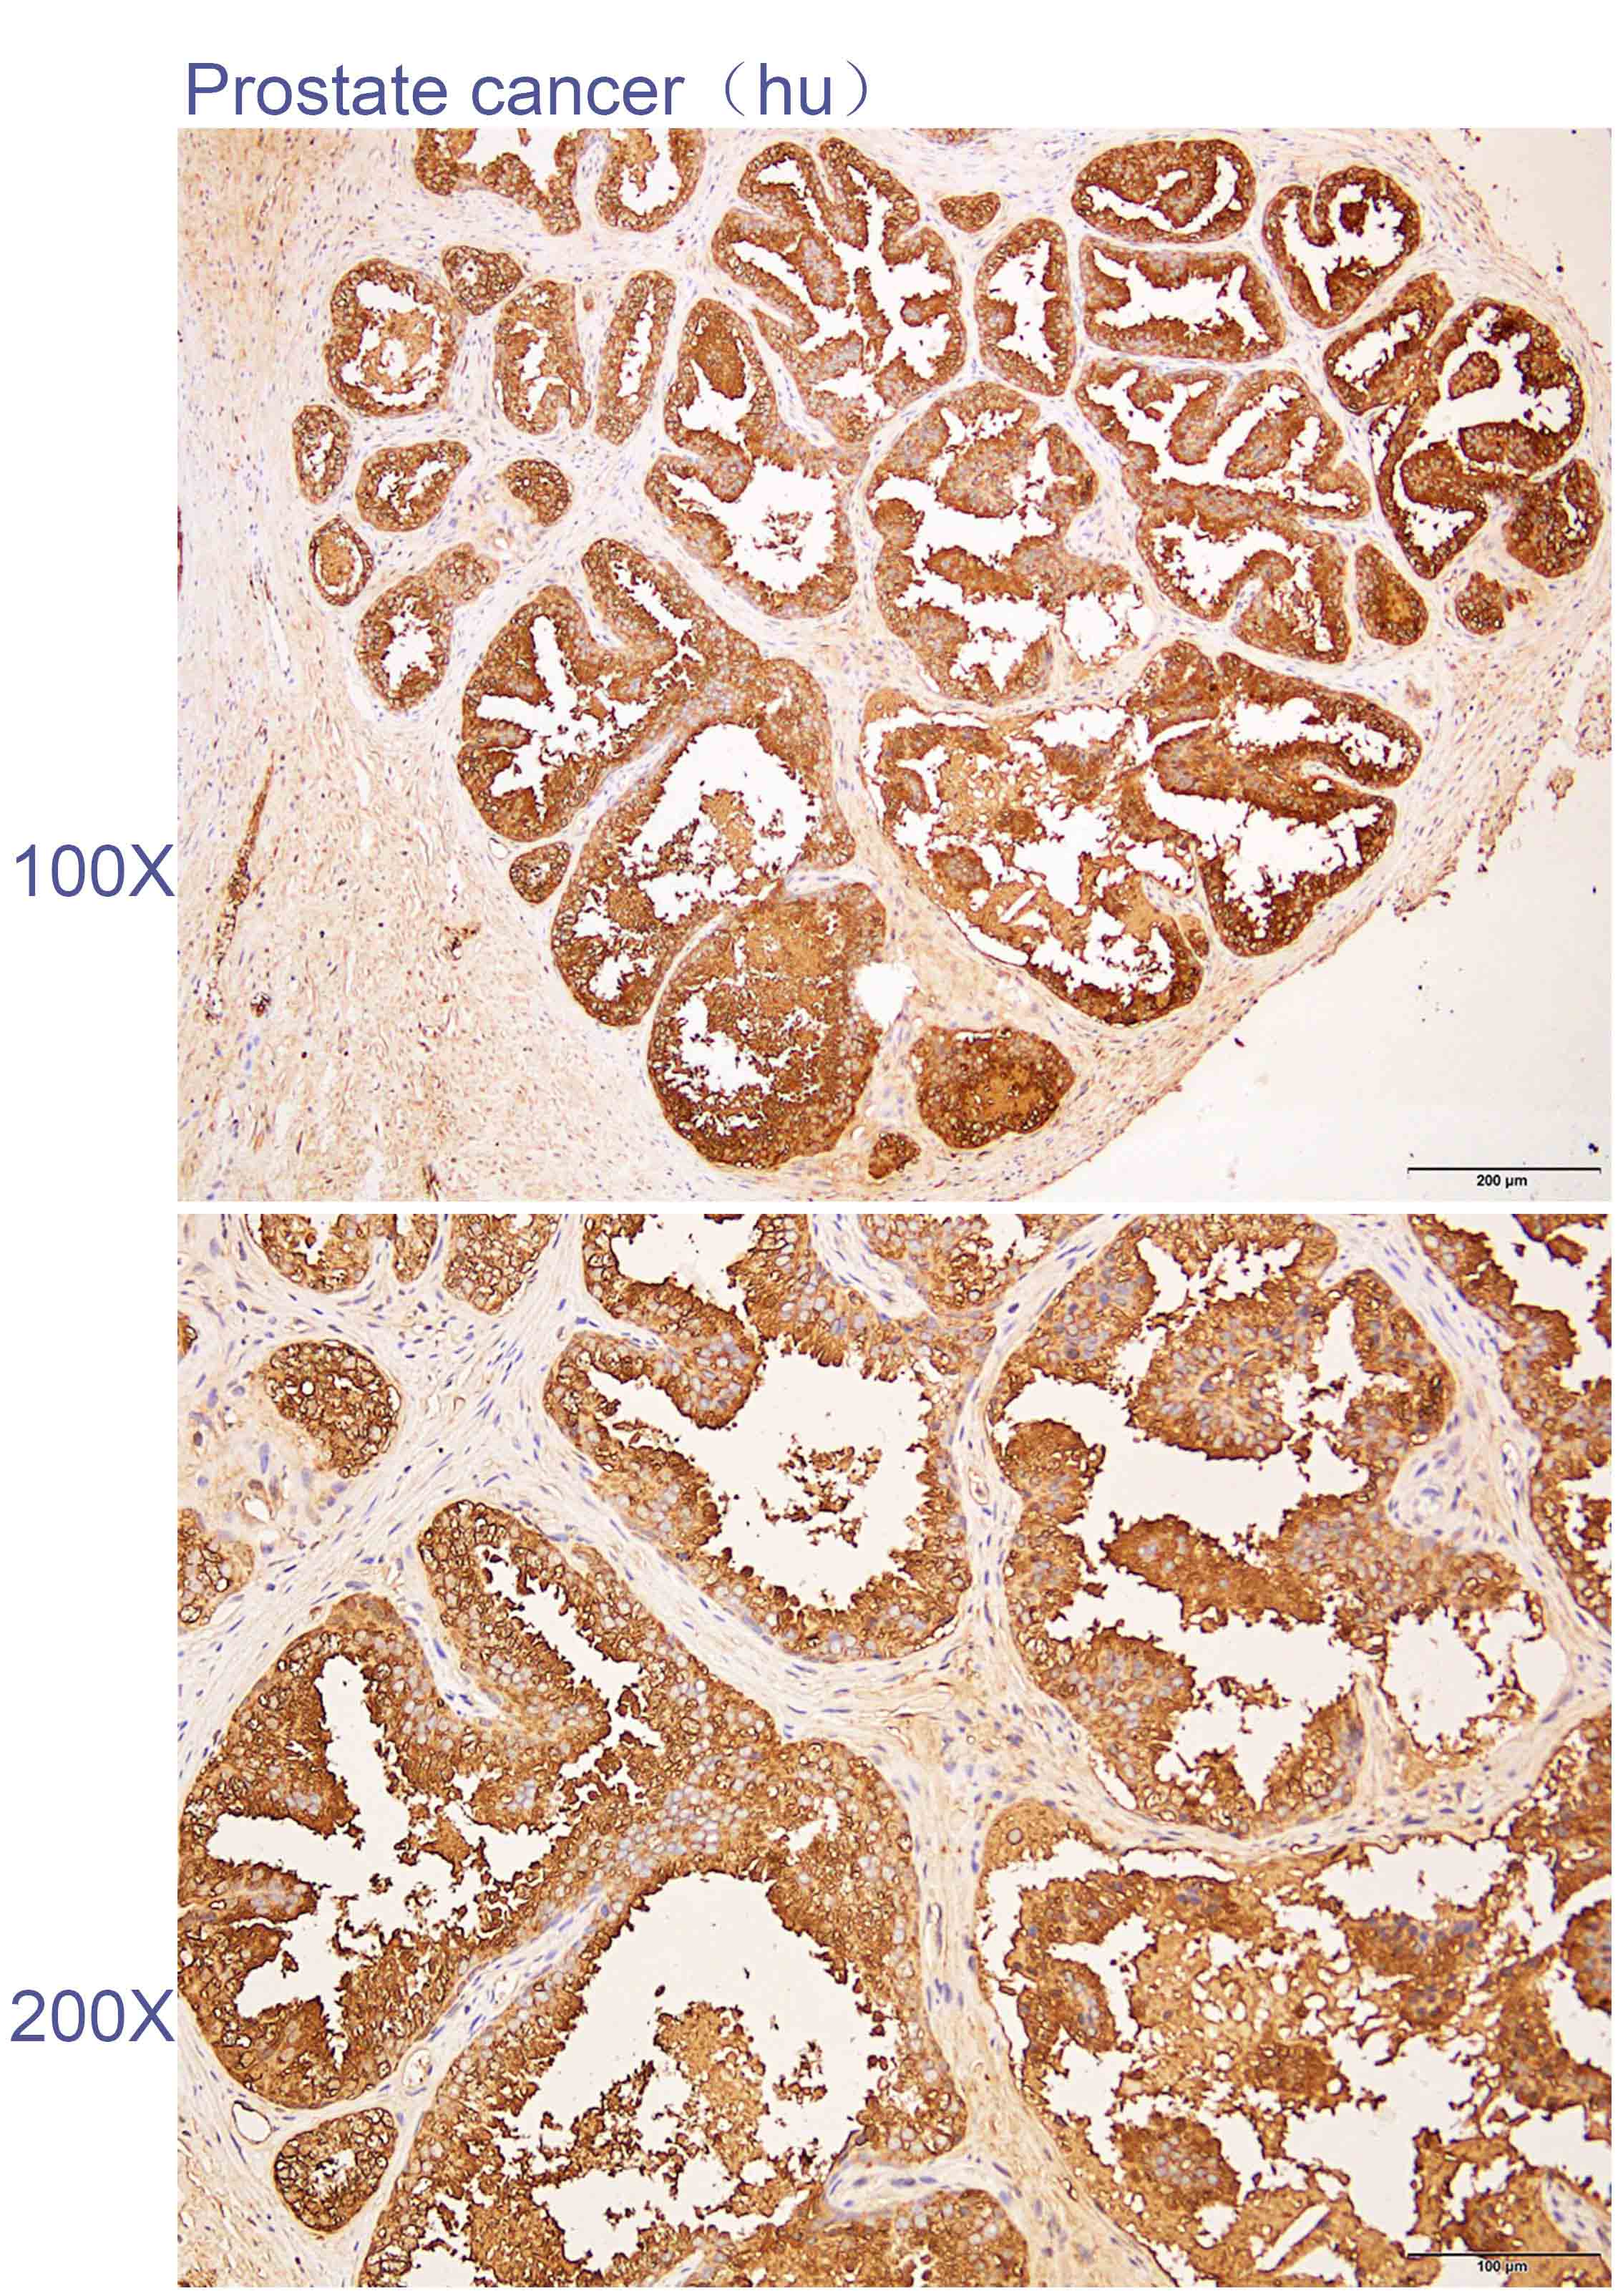

相关产品推荐更多 >
万千商家帮你免费找货
0 人在求购买到急需产品
- 详细信息
- 技术资料
- 免疫原:
Recombinant protein of human ACP3
- 亚型:
IgG
- 保存条件:
Store at -20°C. Avoid freeze / thaw cycles.
- 供应商:
北京索莱宝科技有限公司
- 宿主:
Rabbit
- 应用范围:
WB IHC IF
- 靶点:
ACP3
- 规格:
50ul
Anti-ACP3 Polyclonal Antibody
产品简介
备注:
以上数据均来自公开文献, Solarbio暂未进行独立验证, 仅供参考。
These protocols are for reference only. Solarbio does not independently validate these methods.
实验图

Western blot analysis with ACP3 antibody diluted at 1:2000;Lane: Prostate cancer,Mouse lung

Immunohistochemistry of paraffin-embedded Human prostate cancer with ACP3 antibody diluted at 1:200
产品简介
| 英文名称 | Anti-ACP3 Polyclonal Antibody |
| 别名 | 5'-NT;5'-nucleotidase;Acid phosphatase prostate;ACP 3;ACP3;acpP;Ecto-5'-nucleotidase;PAP;PPAP_HUMAN;Prostatic acid phosphatase;Prostatic acid phosphotase;Thiamine monophosphatase;TMPase; |
| 宿主 | Rabbit |
| 稀释比例 | WB 1:1000-3000. IHC 1:100-300. IF 1:50-200. |
| Gene ID | 55 |
| 保存 | Store at -20°C. Avoid freeze / thaw cycles. |
| Swiss Prot | P15309 |
| 蛋白分子量 | 40/45/48kDa |
| 储存液 | Buffer: PBS with 0.03% Proclin300, 50% glycerol, pH7.3. |
| 亚细胞定位 | Cytoplasm |
| 免疫原 | Recombinant protein of human ACP3 |
| 亚型 | IgG |
| 纯化方法 | Affinity purification |
| 背景资料 | This gene encodes an enzyme that catalyzes the conversion of orthophosphoric monoester to alcohol and orthophosphate. It is synthesized under androgen regulation and is secreted by the epithelial cells of the prostate gland. An alternatively spliced transcript variant encoding a longer isoform has been found for this gene. This isoform contains a transmembrane domain and is localized in the plasma membrane-endosomal-lysosomal pathway. |
| Public Immunogen Range | 1-387aa |
| 克隆类型 | Polyclonal Antibody |
| 交叉反应 | Human Rat Mouse |
| 应用 | WB IF IHC |
| 规格 | 50ul 100ul |
备注:
以上数据均来自公开文献, Solarbio暂未进行独立验证, 仅供参考。
These protocols are for reference only. Solarbio does not independently validate these methods.
实验图

Western blot analysis with ACP3 antibody diluted at 1:2000;Lane: Prostate cancer,Mouse lung
Immunohistochemistry of paraffin-embedded Human prostate cancer with ACP3 antibody diluted at 1:200
风险提示:丁香通仅作为第三方平台,为商家信息发布提供平台空间。用户咨询产品时请注意保护个人信息及财产安全,合理判断,谨慎选购商品,商家和用户对交易行为负责。对于医疗器械类产品,请先查证核实企业经营资质和医疗器械产品注册证情况。
 技术资料
技术资料暂无技术资料 索取技术资料
Anti-ACP3 Polyclonal Antibody
¥960








